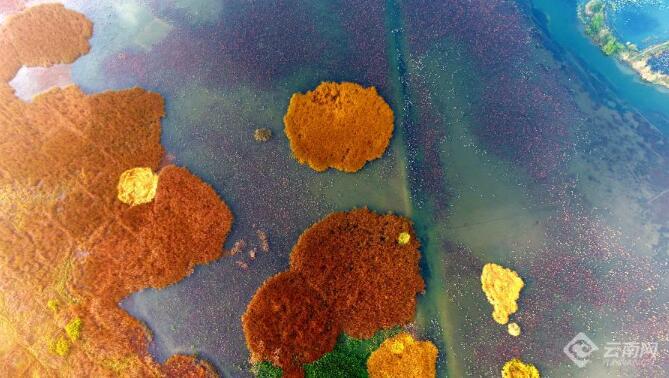

文山普者黑冬日美景迷人眼







冬日里,位于文山壯族苗族自治州丘北縣的普者黑風景區冬日風景美如仙境。置身于這座國家5A級旅游景區內,目之所及山明水凈、層林盡染、候鳥翩躚。湖泊峰林、水上田園等美景無不彰顯大自然的神奇美麗,令游客心曠神怡,贊嘆連連。
云南網通訊員 馬衛忠 攝
本站轉載文章和圖片出于傳播信息之目的,如有版權異議,請在3個月內與本站聯系刪除或協商處理。凡署名"云南房網"的文章未經本站授權,不得轉載。爆料、授權:news@ynhouse.com。




文山普者黑冬日美景迷人眼

冬日里,位于文山壯族苗族自治州丘北縣的普者黑風景區冬日風景美如仙境。置身于這座國家5A級旅游景區內,目之所及山明水凈、層林盡染、候鳥翩躚。湖泊峰林、水上田園等美景無不彰顯大自然的神奇美麗,令游客心曠神怡,贊嘆連連。
云南網通訊員 馬衛忠 攝
本站轉載文章和圖片出于傳播信息之目的,如有版權異議,請在3個月內與本站聯系刪除或協商處理。凡署名"云南房網"的文章未經本站授權,不得轉載。爆料、授權:news@ynhouse.com。
熱門評論